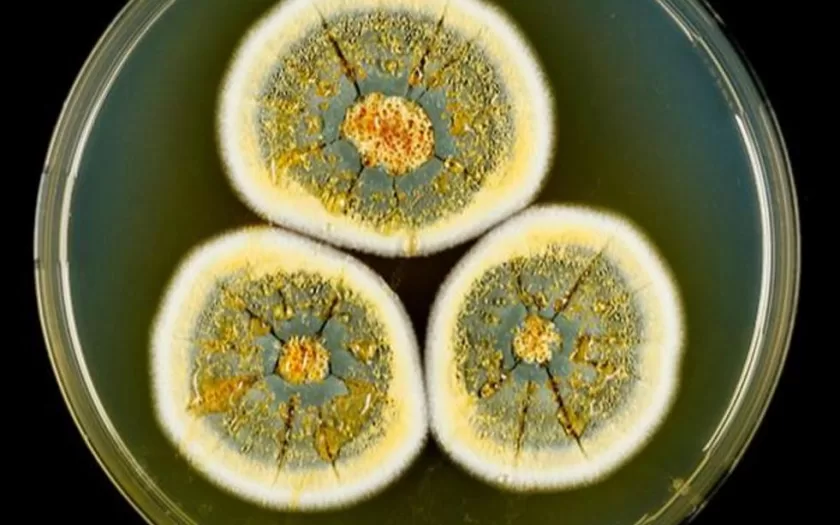
fungos-ufla

A Universidade Federal de Lavras (UFLA) identificou doze novas espécies de fungos nos biomas Cerrado e Caatinga. Estas espécies estão preservadas na Unidade de Recursos Microbiológicos da UFLA (URMICRO/UFLA), em um banco genético mantido a -80°C.
De acordo com a UFLA, esses fungos podem ser utilizados em diversas áreas, como alimentação, medicina, bioinsumos para agricultura e indústria. A pesquisa ressalta o risco de perda dessas espécies, ainda não catalogadas, devido à supressão da vegetação nativa.
A preservação dessas espécies é considerada importante para a bioeconomia. A URMICRO/UFLA atua como um repositório genético para futuras pesquisas e aplicações. A descoberta sublinha a biodiversidade presente nos biomas brasileiros.
Para mais informações sobre o estudo, acesse a matéria completa no Portal da Ciência UFLA: Confira a matéria completa no Portal da Ciência UFLA.